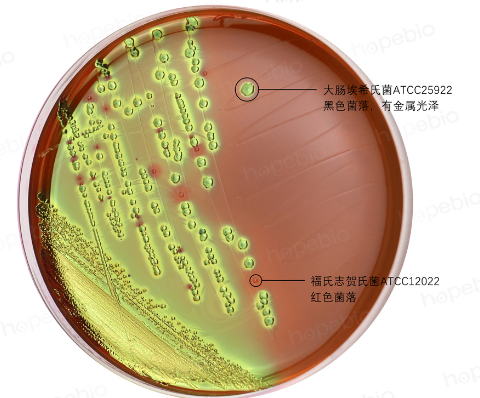
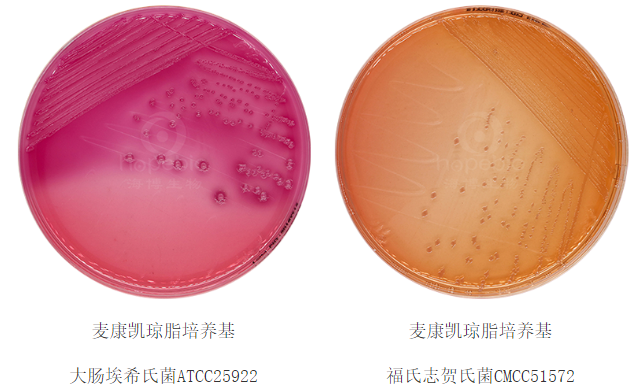
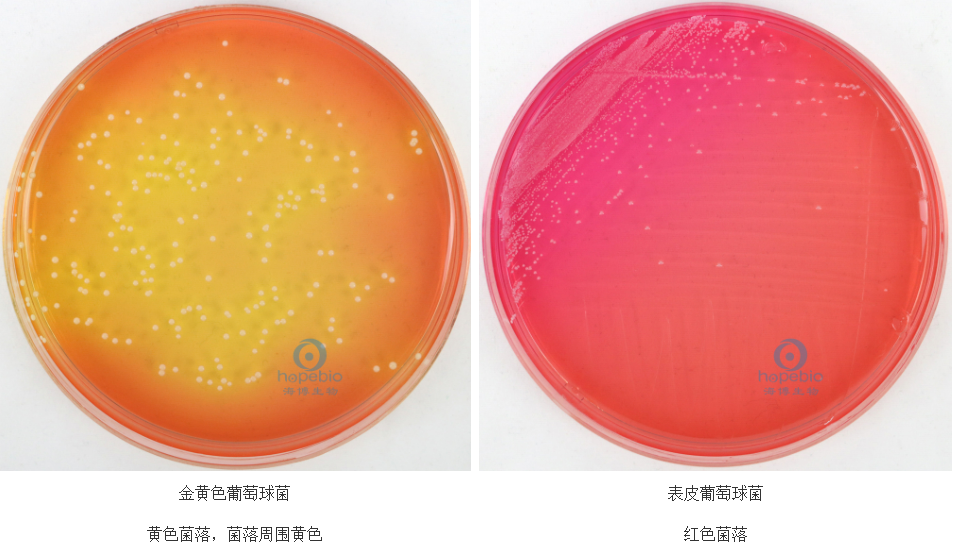

海博微信公众号
海博微信公众号
 海博天猫旗舰店
海博天猫旗舰店


 海博微信公众号
海博微信公众号
 海博天猫旗舰店
海博天猫旗舰店




培养基中的糖类作为微生物生长的重要碳源和能源,其种类及代谢特性直接影响微生物的生理活动。
一、培养基中常见糖类的分类与特性
培养基中的糖类按结构可分为单糖、双糖、多糖及糖醇类等,其分子结构和代谢特性直接影响微生物的生长与代谢。
1、单糖
单糖是微生物最易利用的碳源,无需水解可直接被细胞吸收。
(1)葡萄糖:是自然界分布最广的单糖,分子结构为六碳醛糖(C6H12O6),具有醛基活性基团,为最易同化的碳源,易参与糖酵解途径(EMP途径),是多数微生物的“优先碳源”。
(2)果糖:与葡萄糖同分异构(C6H12O6),为六碳酮糖,在溶液中可转化为葡萄糖被微生物利用,其代谢具有选择性。
(3)半乳糖:属于六碳醛糖,其分子式为C6H12O6,结构式与葡萄糖互为差向异构体,需通过Leloir途径转化为可利用形式。
(4)甘露糖:葡萄糖的C2位差向异构体,常见于真菌细胞壁成分(如酵母甘露聚糖)。
(5)阿拉伯糖:五碳糖,是植物细胞壁半纤维素的组成部分,部分细菌(如假单胞菌)可通过磷酸戊糖途径代谢。
2、双糖
双糖由两分子单糖通过糖苷键连接而成,需经微生物分泌的糖苷酶水解为单糖后利用。
(1)蔗糖(C12H22O11):由葡萄糖和果糖通过α,β-1,2糖苷键连接,广泛存在于植物中,是真菌培养基(如察氏培养基)的常用碳源。
(2)乳糖(C12H22O11):葡萄糖与半乳糖通过β-1,4糖苷键连接,是哺乳动物乳汁的主要成分,仅能被乳糖发酵菌(如大肠埃希氏菌、乳酸菌)利用。
(3)麦芽糖(C12H22O11):两分子葡萄糖通过α-1,4糖苷键连接,是淀粉水解的中间产物,常见于细菌(如芽孢杆菌)和酵母菌的培养基。
3、多糖
多糖由数十至数万单糖聚合而成,需微生物分泌胞外酶水解为单糖或寡糖后吸收。
(1)淀粉:植物储能多糖,分为直链淀粉(α-1,4糖苷键)和支链淀粉(α-1,6分支),是工业发酵中常用的廉价碳源(如谷氨酸发酵)。
(2)纤维素:由葡萄糖通过β-1,4糖苷键连接的线性多糖,是植物细胞壁的主要成分,仅能被纤维素分解菌(如纤维单胞菌)或真菌(如木霉)利用。
(3)糖原:动物储能多糖,结构类似支链淀粉但分支更密集,常见于部分细菌(如大肠埃希氏菌在碳源过剩时合成糖原颗粒)。
(4)几丁质:N-乙酰葡糖胺通过β-1,4糖苷键连接的多糖,是真菌细胞壁和昆虫外骨骼的成分,可被几丁质酶分解菌(如链霉菌)利用。
4、糖醇类
糖醇由单糖还原形成,如甘油(丙三醇)、甘露醇等,常作为特殊碳源用于特定微生物培养。
(1)甘油:三碳糖醇,分子小、水溶性强,是某些厌氧菌(如丙酮丁醇梭菌)和产油微生物(如红酵母)的优良碳源。
(2)甘露醇:甘露醇作为一种六碳糖醇,凭借其高渗性、非还原性和低吸湿性等特性,在医药、食品、微生物培养等领域具有不可替代的作用。其在微生物学中有选择性培养功能(如区分大肠埃希氏菌与致病菌)和作为渗透压保护剂的应用。
(3)山梨醇:与甘露醇互为同分异构体,均为六碳糖醇,是许多微生物的可利用碳源,如乳酸菌和酵母等。
二、糖类对不同微生物的特异性作用机制
1.葡萄糖:细菌的“优先碳源”
能量代谢:大肠埃希氏菌通过糖酵解(EMP途径)将葡萄糖分解为丙酮酸,丙酮酸进一步通过三羧酸循环(TCA)和氧化磷酸化生成ATP。
代谢调控:葡萄糖通过“分解代谢物阻遏”(如cAMP-CRP调控系统)抑制细菌对其他糖类(如乳糖、阿拉伯糖)的利用。例如,在乳糖操纵子模型中,葡萄糖存在时,cAMP水平降低,CRP蛋白无法结合启动子,导致β-半乳糖苷酶基因表达被抑制,细菌优先利用葡萄糖。
实例:金黄色葡萄球菌在含葡萄糖的培养基中2小时即可进入对数生长期,而缺乏葡萄糖时生长速率下降50%以上;大肠埃希氏菌存在“葡萄糖效应”,优先代谢葡萄糖,抑制其他碳源利用,在M9基础培养基中,0.4%葡萄糖即可支持对数生长期。
酵母菌:酿酒酵母在葡萄糖培养基中进行有氧呼吸(生成CO2和H2O)或无氧发酵(生成乙醇和CO2)。
霉菌:青霉菌在葡萄糖培养基中优先合成青霉素,而当葡萄糖耗尽时,转向利用淀粉等多糖,次级代谢产物合成减少。葡萄糖还可通过抑制异柠檬酸裂解酶活性,阻断三羧酸循环的乙醛酸支路,影响真菌的碳代谢分流。
2.果糖:异构酶系统使其代谢具有选择性
枯草芽孢杆菌:通过PTS系统转运果糖,经FruK激酶磷酸化后进入HMP途径。果糖培养基可诱导孢子形成基因表达。
嗜热链球菌:优先利用果糖合成胞外多糖,增强酸奶黏稠度。其果糖激酶活性比葡萄糖激酶高3倍。
3.半乳糖:需Leloir途径转化
乳球菌:gal操纵子在乳糖缺乏时激活,利用半乳糖需额外添加Mn2+辅因子。乳制品发酵中半乳糖代谢影响后酸化过程。
毕赤酵母:半乳糖可诱导AOX1启动子,用于重组蛋白表达调控。甲醇/半乳糖双诱导系统提高外源基因表达效率。
4.乳糖:区分肠道菌的关键碳源
特异性利用:仅乳糖发酵菌(如大肠埃希氏菌)携带乳糖透性酶和β-半乳糖苷酶,可将乳糖水解为葡萄糖和半乳糖。非乳糖发酵菌(如沙门氏菌)因缺乏相关酶系,无法利用乳糖,这一特性被用于伊红美蓝(EMB)培养基(图1)和麦康凯培养基(图2)鉴别肠道菌。
图1 伊红美蓝(EMB)培养基上菌落生长特征
图2 麦康凯培养基上菌落生长特征
工业应用:乳酸菌(如保加利亚乳杆菌、乳酸乳球菌)利用乳糖发酵产生乳酸,是酸奶、泡菜等食品发酵的基础。乳糖代谢产生的乳酸可降低环境pH,抑制杂菌生长,同时赋予食品独特风味。
5.淀粉:工业发酵的经济型碳源
酶解利用:芽孢杆菌(如枯草芽孢杆菌)分泌α-淀粉酶,将淀粉水解为麦芽糖和葡萄糖。例如,在酱油酿造中,米曲霉分泌的淀粉酶分解原料中的淀粉,为后期发酵提供糖源;嗜热脂肪芽孢杆菌在麦芽糖培养基中,麦芽糖可诱导耐热α-淀粉酶分泌,工业酶制剂生产中采用梯度麦芽糖诱导策略。
嗜热链霉菌中,淀粉可诱导抗生素生物合成基因簇表达,阿维菌素产量与淀粉水解速率正相关。
6.蔗糖:真菌形态分化的信号分子
担子菌子实体诱导:香菇菌丝体在含蔗糖(2%-3%)的培养基中,蔗糖可通过激活MAPK信号通路,诱导菌丝扭结形成原基,最终发育为子实体。缺乏蔗糖时,菌丝仅进行营养生长,无法完成生殖阶段。
曲霉产孢调控:黑曲霉在高蔗糖(15%-20%)培养基中,会启动分生孢子形成程序,蔗糖可能通过渗透压信号或碳源代谢物调控孢子壁蛋白基因(如wetA、flbC)的表达;黑曲霉胞外转化酶将蔗糖水解为单糖,柠檬酸发酵中蔗糖比葡萄糖产酸效率提高20%。
7.纤维素与几丁质:真菌降解能力的标志
纤维素分解菌:木霉(如绿色木霉)分泌纤维素酶复合体(包括内切葡聚糖酶、外切葡聚糖酶和β-葡萄糖苷酶),将纤维素分解为葡萄糖。该特性被用于秸秆发酵生产饲料,或生物制浆工业。
几丁质分解菌:绿僵菌在昆虫体表定植时,分泌几丁质酶降解昆虫外骨骼的几丁质,为侵染提供通道。几丁质代谢产物(如N-乙酰葡糖胺)还可作为信号分子,激活真菌毒力相关基因表达。
8.甘露糖:真菌细胞壁合成的前体
酵母细胞壁:甘露聚糖占酵母细胞壁干重的30%-40%,由甘露糖通过α-1,2、α-1,3和α-1,6糖苷键连接而成。
致病真菌黏附:白色念珠菌表面的甘露糖蛋白可与宿主细胞表面的甘露糖受体结合,增强真菌对宿主组织的黏附能力,是感染初期的关键毒力因子。
9.甘露醇:
金黄色葡萄球菌:甘露醇高盐琼脂(MSA)中,致病株发酵甘露醇产酸使酚红变黄,与非致病株区分(图3)。
图3 甘露醇高盐琼脂上菌株生长特征
嗜渗酵母:合成甘露醇作为相容性溶质,在22% NaCl条件下胞内浓度可达1.2M。
10.山梨醇:选择性培养基组分
肠出血性大肠埃希氏菌O157:H7在SMAC培养基中山梨醇不发酵特性(sor-)用于筛选,比野生型菌株(sor+)延迟显色24小时。
双歧杆菌:磷酸酮酶途径代谢山梨醇产生乙酸/乳酸(3:2),调节肠道pH抑制腐败菌。
三、糖类作为微生物分类与鉴别的工具
糖发酵试验:通过观察细菌对不同糖类(如葡萄糖、乳糖、蔗糖)的发酵能力(产酸产气),结合IMViC试验等,可鉴别肠道菌(如大肠埃希氏菌与产气肠杆菌)。乳糖发酵管结果如图4。

图4 乳糖发酵管结果
乳酸菌鉴定:不同种类的乳酸菌对糖类的发酵模式也各不相同。植物乳杆菌能够发酵阿拉伯糖、木糖等五碳糖,而嗜酸乳杆菌对这些糖类的发酵能力较弱。通过检测乳酸菌对多种糖类(如葡萄糖、果糖、半乳糖、麦芽糖、蔗糖等)的发酵特性,可以初步判断乳酸菌的种类,为后续的菌种筛选和应用提供基础。
四、相关产品
本公司部分含有糖类的培养基:
|
产品货号 |
产品名称 |
规格 |
产品说明及用途 |
|
HB0231 |
250g/瓶 |
用于青霉、曲霉鉴定及保存菌种用(GB标准) |
|
|
HB0107 |
250g/瓶 |
弱选择性培养基,用于分离肠道致病菌,特别是大肠杆菌 |
|
|
HB6238 |
250g/瓶 |
用于肠道致病菌的选择性分离培养 |
|
|
HB4128 |
250g/瓶 |
用于金黄色葡萄球菌的选择性分离培养 |
|
|
HB0136 |
250g/瓶 |
用于细菌的糖发酵试验 |
|
|
GB004 |
20支/盒 |
用于大肠杆菌生化鉴定 |
|
|
SN016 |
20支/盒 |
用于单增李氏菌生化鉴定 |
|
|
GB067 |
20支/盒 |
用于变形杆菌与单增李斯特菌的GB检测 |
|
|
GB169 |
20支/盒 |
用于小肠结肠炎耶尔森氏菌的生化鉴定 |
|
|
HB0237-2 |
250g/瓶 |
用于食品中霉菌和酵母菌总数的测定 |
|
|
HB0110 |
250g/瓶 |
用于大肠菌群、粪大肠菌群、大肠杆菌的测定 |
|
|
HB0121 |
250g/瓶 |
用于大肠杆菌O157的选择性分离培养 |
注:本文属海博生物原创,未经允许不得转载。
下一篇:没有了!
| 相关文章: | ||



